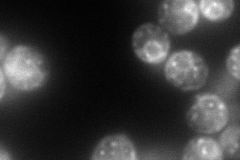
YOR016C
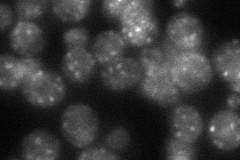
YOR016C
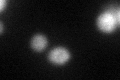
YOR016C
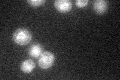
YOR016C

View description
Protein with similarity to Emp24p and Erv25p, member of the p24 family involved in ER to Golgi transport
Localization:
Intensity:
Fold change:
Significance:
-
C’ GFP library in SD

ER44.35 -
N' NOP1pr-GFP in SD
ER,punctate160.805 -
N' TEF2pr-mCherry in SD

missing0 -
N' NATIVEpr-GFP in SD
punctate51.5711 -
N' TEF2pr-VC and Cyto-VN in SD

#N/A0 -
C’ GFP library in SD+DTT
ER36.870.83No -
C’ GFP library in SD+H2O2

ER42.160.95No -
C’ GFP library in Starvation Media
ER39.340.88No -
C’ GFP library on the background of Pup2-DaMP

ER -
C’ GFP library on the background of CCT mutant

ER46.79111.05501No
